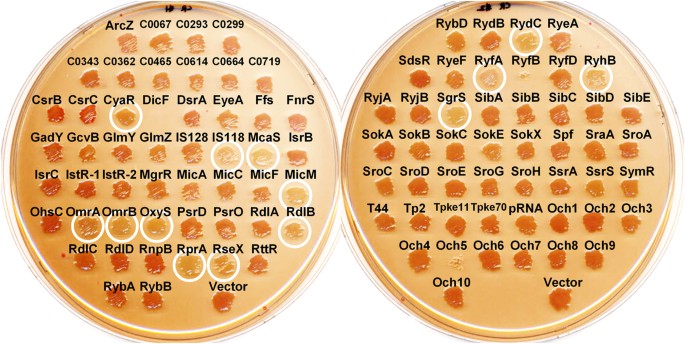
figure 7

Abstract
Bacterial small RNAs (sRNAs) are known regulators in many physiological processes. In Escherichia coli, a large number of sRNAs have been predicted, among which only about a hundred are experimentally validated. Despite considerable research, the majority of their functions remain uncovered. Therefore, collective analysis of the roles of sRNAs in specific cellular processes may provide an effective approach to identify their functions. Here, we constructed a collection of plasmids overexpressing 99 individual sRNAs and analyzed their effects on biofilm formation and related phenotypes. Thirty-three sRNAs significantly affecting these cellular processes were identified. No consistent correlations were observed, except that all five sRNAs suppressing type I fimbriae inhibited biofilm formation. Interestingly, IS118, yet to be characterized, suppressed all the processes. Our data not only reveal potentially critical functions of individual sRNAs in biofilm formation and other phenotypes but also highlight the unexpected complexity of sRNA-mediated metabolic pathways leading to these processes.
Similar content being viewed by others
Introduction
Expression of about a hundred species of small RNAs (sRNAs) has been experimentally confirmed in Escherichia coli1,2,3,4,5,6,7,8. sRNAs interact with specific targets, such as protein, RNA or DNA to perform their respective functions and have received significant attention as central regulators in a variety of cellular processes9,10,11,12,13,14,15. The majority of functionally characterized sRNAs base-pair with mRNA targets, thereby affecting mRNA stability and/or translational activity. Approximately one-third of the sRNAs identified to date strongly interact with Hfq protein, which enhances sRNA stability and facilitates hybridization to their target mRNAs16,17,18.
Bacteria can establish biofilm, a structure comprising multicellular aggregates embedded in extracellular matrix that adhere to each other and/or surfaces to protect against damaging environments. Biofilm formation occurs from both biotic and abiotic surfaces, thereby leading to severe pathogenic and industrial problems, such as increased antibiotic resistance, chronic infection, growth of bacteria in medical devices and corrosion of industrial pipes19. Thus, the decision-making process of bacteria to develop biofilm or not should be precisely and dynamically regulated in response to environmental changes, owing to the high energy costs and irreversibility of the process20,21. Development of biofilm is one of the most complex physiological processes in bacteria. Several genes required for biofilm development have been investigated via microarrays22,23,24 and systematic knockout mutant studies25. Generally, flagella-based motility, cell surface appendages, such as type I or curli fimbriae, lipopolysaccharide (LPS), other genes related to the cell membrane and exopolysaccharide (EPS) are considered important factors for initial attachment of cells and maturation of complex biofilm structure26.
sRNAs usually respond to specific environmental stress conditions and regulate a number of genes participating in stress adaptation15,27. Moreover, many sRNAs modulate outer membrane or surface proteins in E. coli and/or Salmonella enterica28,29. Accordingly, it is speculated that sRNAs are involved in regulation networks linking environmental cues and metabolic changes during development of biofilm. Since biofilm formation is a phenotype that could be generated from comprehensive response to various cellular stress factors, the regulatory mechanisms involved remain poorly understood. Therefore, collective analysis of sRNAs affecting biofilm formation and related phenotypes may provide insights into the cellular mechanisms underlying this process. Previously, the group of Gottesman examined the effects of a collection of plasmids overexpressing 26 Hfq-dependent sRNAs on rpoS and flhDC expression and swimming motility30,31. Although the collection only contained part of the sRNAs experimentally validated in E. coli, this approach led to the identification of both previously identified and novel sRNAs. For instance, in addition to two previously defined sRNAs (DsrA and RprA), ArcZ was identified as a sRNA involved in rpoS activation, McaS as an sRNA activator and ArcZ, OmrA, OmrB and OxyS as negative regulators of flhDC expression and swimming motility.
sRNAs controlling expression of flhDC, rpoS or csgD (encoding the key biofilm regulator), such as ArcZ, DsrA, RprA, McaS, OmrA/OmrB and GcvB, have been shown to affect biofilm formation32. While sRNAs affecting motility through changes in flagella expression appear to affect biofilm formation, this finding cannot be generalized, since only a limited number of sRNAs have been examined to date. In the current study, we expressed 99 experimentally verified sRNAs, with the aim of evaluating their effects on biofilm development processes and establishing the relationship between motility and biofilm formation. In terms of motility, we examined the effects of sRNAs, not only on swimming but also swarming motility. Other biofilm related-phenotypes, such as type I and curli fimbriae formation, were additionally assessed.
Overall, we identified 33 sRNAs that significantly affect biofilm formation and related phenotypes of swimming and swarming motilities, type I fimbriae or curli fimbriae formation. However, no consistent correlations among these were evident, except that all five sRNAs suppressing type I fimbriae formation also inhibited biofilm formation. Even two homologous sRNAs, OmrA and OmrB, which were previously reported as repressors of curli formation33, induced different swimming and swarming motility phenotypes. Interestingly, IS118, which has not been characterized as yet, suppressed all the processes examined. We also identified new sRNAs, such as CsrB, DicF, GadY, IS118, Och5, SdsR and SgrS, which directly or indirectly target biofilm-related genes csgD, flhD and/or pgaA. Our collective findings disclose potentially critical individual sRNAs involved in biofilm formation or related phenotypes and highlight the unexpected complexity of sRNA-mediated metabolic pathways leading to these processes.
Results
Construction of plasmids expressing sRNAs
Although several hundred sRNAs have been predicted in E. coli, only ~100 have been experimentally validated using northern blot, microarray and RNA-seq analyses to date1,2,3,4,5,6,7,8. Several of the experimentally verified sRNAs have not been functionally characterized as yet (Fig. 1, Supplementary Table 1). Here, we overexpressed a collection of sRNAs, with a view to characterizing their physiological functions in biofilm formation, motility and fimbriae formation. To this end, we constructed plasmids overexpressing 99 experimentally validated sRNAs via IPTG induction. The sRNA sequences were cloned into the RNA expression vectors pHM-tac, pHMB1 or pHMB2 (Supplementary Fig. 1). For sRNAs with known 5′ ends, we designed expression plasmids to facilitate transcription from this start site. However, if the 5′ end was not adenine, an extra adenine residue was added to the 5′ end of sRNAs to facilitate efficient transcription. In cases where 5′ ends were only predicted, ~20 nt upstream chromosomal sequences were added. For the 3′ end, >25 nt downstream chromosomal sequences were added to the predicted 3′ end or the identified termination site. If the cloned fragment did not contain a termination signal, transcriptional termination could occur at the rnpB terminator adjacent to the cloning site. The full sequences of cloned fragments for sRNA expression are presented in Supplementary Table 2.
To validate expression from RNA expression plasmids, total RNAs purified from 1 mM IPTG-induced cells transformed with individual plasmids were analyzed via northern blot. Since expressed RNAs contain the rnpB terminator sequence if a transcription termination signal is not included in the cloned fragment or does not lead to complete termination, we employed an oligonucleotide probe, rnpBXbI, complementary to the rnpB terminator. The rnpBXbI probe was used to successfully detect expression of 72 sRNAs (Fig. 2a). Owing to the presence of the rnpB terminator sequence, the observed lengths of expressed sRNAs were ~50 nt longer than the expected sizes. We additionally observed minor bands, which would be transcriptionally terminated further downstream and their processed products. Expression of other sRNAs was analyzed with specific probes for each sRNA. To reduce the number of individual steps for northern analysis with specific probes, we applied a mixture of 5 to 8 different probes to one membrane. Using this protocol, expression of 21 sRNA species was verified (Fig. 2b). The expression of the remaining 6 species was validated with the corresponding probes (Fig. 2c). Ultimately, IPTG-induced expression of all 99 sRNAs was confirmed.
Northern blot analysis of overexpressed sRNAs. MG1655 cells containing each sRNA-expressing plasmid were grown to OD600 ~ 0.6 and induced with 1.0 mM IPTG for 20 min.
Total RNAs (10 μg) were subjected to northern blot. Membranes were probed with rnpBXb1 (a), specific oligonucleotide mixes (b), or each specific oligonucleotide (c). RNA sizes were estimated using Century marker (Ambion), indicated on the left. 5S rRNA stained with ethidium bromide was also used as a loading control. Overexpressed sRNAs are marked by arrowheads.
Interestingly, northern blot data using a mixture of probes revealed possible regulatory networks between some sRNAs. For instance, overexpression of RyeA and SdsR led to mutual reciprocal repression, which was also observed with CsrB and CsrC. In addition, increased expression of GlmZ was observed upon GlmY sRNA overexpression, consistent with a previous report34. All RNAs, except C0362 and RyeF, were detected with the expected sizes. C0362 sRNA, expected to yield a ~386 nt product, was detected as ~200 and ~230 nt bands (Fig. 2c), while RyeF, predicted as 388 nt, was detected as a ~280 nt species (Fig. 2c). The reasons underlying these discrepancies remain to be elucidated.
Small RNAs involved in biofilm formation
Firstly, the roles of overexpressed sRNAs in biofilm formation, an important group behavior, were analyzed. Individual E. coli cells containing each sRNA-overexpressing plasmid were induced with 1 mM IPTG and the extent of biofilm formation was measured. The extent of attached cells varied among experiments, depending on the incubation temperatures and times, E. coli strain tested, nutrient conditions and surface material (data not shown). Since biofilm formation on round bottom polystyrene (PS) plates at 30oC was the most reproducible with minimal deviation, we analyzed the effects of individual sRNAs on biofilm formation under these conditions using the E. coli strain MG1655 grown on LB (Fig. 3a,b). Overexpression of Och5, CsrC, RseX, FnrS, SgrS and GcvB induced >1.5-fold increase in biofilm formation, compared to control cells (containing the pHMB1 vector). In contrast, IS118, RyfD, SroC, SdsR, RyfA, McaS, OmrA, ArcZ, MicM, DicF, RybB and DsrA led to a >1.5 fold decrease in biofilm development. Since sRNAs, such as Och5, GcvB, RyfA and DicF, caused slower cell growth upon overexpression (Fig. 3a,b), one possibility is that this cell growth inhibition is related to biofilm formation. However, these toxic sRNAs participated in inhibiting (RyfA, DicF) as well as enhancing biofilm formation (Och5, GcvB), suggesting no direct effects of growth inhibition on biofilm formation.
Effects of small RNA overexpression on biofilm formation in E. coli.
(a) To characterize the biofilm forming ability of E. coli overexpressing sRNAs, a collection of strains containing each sRNA-expressing plasmid were grown in LB containing 1 mM IPTG and 100 μg/mL ampicillin at 30 °C for 12 h and the amount of biofilm attached to 96-well round bottom polystyrene microtiter plates was measured via crystal violet staining. (b) The level of biofilm formation (OD550) was expressed relative to cell growth (OD595) and termed ‘biofilm index’. The biofilm index value was normalized to control cells containing plasmid vector (pHMB1) and designated ‘relative biofilm index’. (c) Effects of ArcZ, DsrA and SdsR sRNAs on biofilm formation in the MG1655Δhfq background. (d) Comparison of relative biofilm formation by MG1655 and MG1655Δhfq strains. Relative biofilm indexes are shown on a bar graph (axis on the left) and the growth of each strain as a line graph (axis on the right).
Hfq-dependent sRNAs usually require Hfq proteins for in vivo stability and function16,18. To determine whether Hfq protein is required for modulating biofilm formation by sRNAs, we examined the Hfq dependency of three selected inhibitory sRNAs (ArcZ, DsrA and SdsR), previously identified as Hfq-associated sRNAs30,35,36, using Δhfq cells (Fig. 3c,d). Deletion of hfq induced a significant decrease in biofilm formation. Notably, overexpression of three sRNAs led to no further inhibition, suggesting that biofilm regulation by these sRNAs occurs through Hfq.
Moreover, ArcZ and DsrA, rpoS-activating sRNAs, inhibited biofilm formation, while RprA, another rpoS-activating sRNA, had little effect, indicating that inhibition of biofilm by the two former sRNAs is not directly related to RpoS.
We examined dosage effects of some sRNAs affecting biofilm formation to confirm that sRNAs are major contributors to this process. Since expression of sRNAs from the RNA expression vector is known to increase with the IPTG concentration37, the relationship between the IPTG and the phenotypic changes was analyzed. The activation or repression of biofilm formation also increased with the IPTG concentration (Supplementary Fig. 2), suggesting that biofilm phenotypes are proportional to sRNA concentrations.
Small RNAs involved in swimming/swarming motility
Flagella-based motility is generally considered important for initial attachment, biofilm expansion and dispersion of cells from surfaces of biofilm20,26,38,39. Two types of motility have been identified, depending on the bacterial flagella40. Swimming motility is an individual and random-directional movement in liquid medium and essential for initial attachment to develop biofilm. Swarming motility is a coordinated bacterial social movement across the top of solid surface, accompanied by hyper-flagellation critical for surface colonization after initial attachment. Here, we further investigated whether these modes of motility are altered by individual sRNAs in correlation with biofilm formation. Overnight cultures of cells containing plasmids capable of overexpressing sRNAs upon IPTG induction were directly spotted on soft agar plates containing IPTG for assay of swimming or swarming motility. Nine sRNAs (DsrA, GlmY, IS118, OmrA, OxyS, ArcZ, DicF, Och5 and RyfB) induced a >1.5 fold decrease, while MicA promoted a >1.5 fold increase in swimming motility (Fig. 4). In terms of swarming motility, more sRNAs were effective (Fig. 5). In total, 25 sRNAs (OmrA, RyfD, DsrA, MicC, RdlB, SdsR, RdlC, Och5, CsrC, GadY, RyeF, RyhB, GcvB, RprA, SgrS, RseX, ArcZ, IS118, MicA, RyfA, CsrB, RydC, DicF, OxyS and RyfB) reduced swarming motility by >1.5-fold (Fig. 5). Conversely, McaS induced a significant increase in swarming motility.
Effects of sRNA overexpression on swimming motility.
(a) Swimming motility was investigated on soft agar plates (0.3% Bacto Agar, 1% tryptone, 0.5% NaCl) containing 1 mM IPTG and 100 μg/mL ampicillin. Assays were performed at 30 °C for 12 h. A representative image of at least three independent experimental sets is shown. (b) The diameter of the swimming circle was compared to that of the control strain harboring the pHMB1 vector. Results are presented as the average of at least three separate experiments and error bars represent standard deviation. Normalized motility of the control strain is indicated with a black bar and strains displaying >1.5-fold changes with a dark grey bar.
Effects of sRNA overexpression on swarming motility.
(a) Swarming motility was investigated on soft agar plates (0.6% Eiken Agar, 0.5% glucose, 1% tryptone, 0.5% yeast extract, 0.5% NaCl) containing 1 mM IPTG and 100 μg/mL ampicillin. Overnight cultures of MG1655 cells harboring each sRNA-expressing plasmid were inoculated onto plates and incubated at 37 °C for 16 h. A representative image of at least three independent experimental sets is shown. (b) The distance of the swarming branch was measured and compared to the distance of control strain harboring the pHMB1 vector. Results are presented as the average of at least three separate experiments and the error bars represent standard deviation. Normalized motility of the control strain is indicated with a black bar and strains displaying >1.5-fold changes with a dark grey bar.
Among the nine sRNAs that suppressed swimming motility, DsrA, IS118, OmrA, OxyS, ArcZ, DicF, Och5 and RyfB also induced a significant reduction in swarming motility. On the other hand, GlmY led to severely reduced swimming motility, but mild reduction of swarming motility. SgrS, an sRNA suppressing glucose transport41, inhibited swarming motility significantly but swimming motility mildly, possibly attributable to inhibiting chemotaxis through repression of glucose transport. CsrB and CsrC, both of which antagonize CsrA protein, a carbon storage regulator, also caused a severe reduction in swarming motility and mild reduction in swimming motility, probably through inhibition of glucose metabolism. Other sRNAs that reduced swarming motility severely and swimming motility mildly were RprA, SdsR, GcvB, RyfD, GadY, RyhB and RyfA. Our results indicate that swimming and swarming motility mechanisms share common pathways.
Notably, however, MicA sRNA, a post-transcriptional regulator of the outer membrane protein, OmpA42,43, increased swimming motility but almost eliminated swarming motility. In contrast, overexpression of McaS led to increased swarming motility but reduced swimming motility, suggesting that MicA and McaS affect their target genes independently of each other and their control levels are possibly located downstream of the common pathways.
Small RNAs involved in type I and curli fimbriae formation
In addition to flagella-based swim/swarm motility, cell surface appendages, such as type I fimbriae and curli fimbriae, are implicated in biofilm formation20,26,44,45. Type I fimbriae are rod-shape adhesive organelles surrounding the cell surface, thought to be critical for initial stable, irreversible attachment in biofilm development. Since mannose-specific adhesin, FimH, appears at the tip of type I fimbriae, expression of these organelles could be indirectly determined via examining agglutination of mannose-rich yeast cells46,47. Curli fimbriae are also adhesive protein appendages that play a role in cell-surface and cell-cell interactions. Formation of curli fimbriae is thought to be essential for development of mature biofilm. The level of curli expression can be monitored by the red color of colonies on Congo red indicator plates44. Specifically, cells expressing curli fimbriae appear as red colonies on plates stained with Congo red, whereas those lacking curli fimbriae remain as white colonies. In the current study, we examined the effects of sRNA overexpression on biosynthesis of both type I and curli fimbriae and how these phenotypic changes are related to biofilm formation.
MG1655 cells overexpressing DsrA, IS118, MicA, MicM and RybB appeared severely deficient in type I fimbriae synthesis (Fig. 6) in correlation with their ability to inhibit biofilm formation (Fig. 3). Transcription of MicA and RybB is dependent on sigma factor σE, which is activated by cell envelope stress and these sRNAs regulate mRNAs of distinct and shared targets48. In particular, RybB and MicA suppress expression of fimA encoding a major subunit of type I fimbriae and fimB encoding recombinase required for fimA promoter inversion, respectively49. However, no involvement of DsrA, IS118 and MicM in type I fimbriae has been reported to date.
Effects of sRNA overexpression on type I fimbriae phenotypes.
Formation of mannose-specific type I fimbriae was determined by the ability of each strain to agglutinate yeast cells. Strains were grown in LB containing 1 mM IPTG and 100 μg/mL ampicillin without shaking at 37oC and mixed with the same volume of yeast suspension (0.5% w/v, PBS) in a 96-well titer plate. Crystal violet was added to enhance observation. The data are representative of at least three independent experiments. The ΔfimA strain was used as a type I fimbriae-deficient control. Strains that appeared type I fimbriae-deficient are indicated with circles.
Curli synthesis was affected by a variety of sRNAs (Fig. 7). MG1655 cells overexpressing CyaR, IS118, McaS, MicM, OmrA, OmrB, OxyS, RdlB, RprA, RseX, RydC, RyfA, RyhB and SgrS appeared curli-deficient. The major regulator of curli fimbriae, CsgD, was recently identified as a gene negatively regulated by several sRNAs, including McaS, OmrA, OmrB, RprA, RydC and GcvB50,51. Our findings are consistent with these results, with the exception of GcvB, which did not affect curli expression in our experiments. Overexpression of CsrB or CsrC, both inactivators of CsrA, resulted in a more reddish color on the Congo red indicator plate.
Effects of sRNA overexpression on curli fimbriae phenotype.
Strains harboring the sRNA library were assayed on a Congo red agar plate (LB agar without NaCl containing 1 mM IPTG, 100 μg/mL ampicillin, 40 μg/mL Congo red, 20 μg/mL Coomassie blue) to evaluate expression of curli fimbriae. Overnight cultures were streaked on agar plates and grown at 28 °C for 48 h. Strains showing curli fimbriae deficiency are indicated with white circles.
Effects of sRNA overexpression on biofilm-related genes
Effects of overexpression of the 33 sRNAs on expression of three biofilm-related genes, csgD, flhD and pgaA were examined using each lacZ fusion. The transcriptional regulator CsgD is known to be a key player in the regulatory circuit for biofilm formation52. Besides OmrA, OmrB, RprA and McaS that were previously reported as negative regulators of csgD33,50,53,54, CsrB, DicF, IS118, Och5 and SgrS reduced the expression of the csgD-lacZ translational fusion by >1.5 fold (Fig. 8a). All csgD-repressing sRNAs except Och5, DicF and CsrB decreased curli fimbriae formation. As for Och5 and DicF, we were unable to evaluate their effects on curli fimbriae formation because of poor growth of cells on assay conditions for curli expression (Fig. 7). CsrB, which showed a moderate repression of csgD expression, caused a more reddish color on Congo red plates (Fig. 7). Since, however, other csgD-unlinked sRNAs, such as OxyS and RseX, also repressed curli formation (Fig. 7), curli-deficiency can occur without suppression of csgD expression. Och5 and SgrS caused an increase in biofilm formation, while DicF and IS118 inhibited biofilm development (Fig. 3), suggesting that csgD expression alone does not explain biofilm formation. We analyzed possible interactions between newly identified csgD-repressing sRNAs (DicF, IS118, Och5 and SgrS) and csgD mRNA by using electrophoretic mobility shift assay (EMSA) (Supplementary Fig. 3). Only Och5 formed a complex with the csgD 5′-UTR, suggesting that it negatively regulate csgD expression by direct base-pairing with the 5′-UTR. The other sRNAs DicF, IS118 and SgrS may not directly target the csgD 5′-UTR. We also confirmed that RprA, OmrA and OrmB can form complexes with the csgD 5′-UTR in vitro.
Effects of overexpressed sRNAs on expression of csgD’-, flhD’-, and pgaA’-‘lacZ translational fusions.
E. coli GSO559 (PBAD-csgD’-‘lacZ) (a), GSO563 (PBAD-flhD’-‘lacZ) (b) and GSO567 (PBAD-pgaA’-‘lacZ ) (c) were treated with arabinose and IPTG. β-galactosidase activities were measured after the arabinose and IPTG induction. Cells overexpressing RyfB were not used for β-galactosidase due to their severe growth defect. Results are presented as the average of at least three independent experiments and error bars correspond to standard deviation. The control strains carrying the vector are indicated with a black bar and strains displaying >1.5-fold changes with a dark grey bar.
Transcriptional regulator FlhDC can be involved in biofilm formation by playing a key role in the flagellar assembly process55. We found that expression of flhD-lacZ was repressed upon overexpression of OmrA, ArcZ, OxyS, SdsR and DicF by >1.5-fold (Fig. 8b). Involvement of DicF in down-regulation of flhD expression has not been reported to date31,54. All these sRNAs showed a reduced swarming phenotype, while McaS that activates flhD expression caused an increase in swarming motility, suggesting that flhD expression is closely related to the swarming phenotype. In addition, overexpression of OmrA, ArcZ, DicF and SdsR, but not OxyS, led to a reduction in biofilm formation (Fig. 3). We also identified McaS as activating flhD-lacZ expression. McaS has been known as a positive regulator of flhD54. Possible interaction of newly found flhD-repressing sRNA DicF with flhD mRNA was also analyzed using EMSA (Supplementary Fig. 3). We did not detect any DicF-flhD 5′-UTR complexes, suggesting that the flhD 5′-UTR may not be the direct target mRNA of DicF. Interestingly, we did not find complexes between the flhD 5′-UTR and OmrA or OmrB either, even though De Lay and Gottesman31 suggested their binding to the flhD 5′-UTR through mutational analysis. No interaction of SdsR was observed either, which could be predicted from the previous mutagenesis data31.
The pgaABCD operon encodes the enzymes and porin responsible for synthesis of a biofilm polysaccharide adhesion56. We found that CsrB, CsrC, DicF, McaS, GadY and SdsR activated pgaA-lacZ expression by >1.5 fold (Fig. 8c). In addition to previously reported McaS, CsrB and CsrC57,58,59, we identified GadY, DicF and SdsR as new positive regulators of pgaA. However, only CsrC (and CsrB) increased biofilm formation.
Biofilm formation or related phenotypes in strains lacking sRNAs
We also examined biofilm formation or related phenotypes in mutant strains lacking sRNAs. We tested the thirty-three sRNAs that were shown to affect these cellular processes upon overexpression. sRNA knock-out strains containing the RNA expression vector were tested under the same experimental conditions employed with sRNA-overexpressing cells. MG1655∆dsrA, a mutant strain lacking DsrA, increased biofilm formation, while MG1655∆gcvB decreased biofilm formation (Fig. 9a,d). MG1655∆arcZ displayed a slight increase in swimming motility (Fig. 9b,e). These phenotypes were opposite to the overexpression phenotypes, suggesting that the chromosomally-expressed sRNAs give the same phenotypes in our experimental conditions. MG1655∆micC showed a slightly reduced biofilm formation, suggesting that MicC is also involved in inducing biofilm formation although its overexpression causes no further increase of biofilm formation (Fig. 3). MG1655∆rseX showed slightly reduced swarming motility (Fig. 9c,f). As overexpression of RseX also suppressed swarming motility (Fig. 5), it seems likely that proper amounts of RseX are needed for efficient swarming motility. It was intriguing that only for the few cases the deletion of sRNA genes had effects on biofilm formation or motility phenotypes. In addition, we did not find any sRNA showing significant changes in type I and curli fimbriae formation except for the arcZ knock-out that showed a slightly reduced type I fimbriae formation and reduction of curli fimbriae (Fig. 10). We reason that some sRNAs may not be expressed enough to affect these cellular processes in our experimental conditions or there might be redundancy of sRNAs acting on the processes.
Biofilm formation and swimming/swarming motility in strains lacking sRNAs.
Biofilm formation and swimming/swarming motility were analyzed in strains lacking each of 33 sRNAs, which were shown to significantly affect biofilm formation and related phenotypes. sRNA knock-out strains containing the RNA expression vector were tested under the same experimental conditions employed with sRNA-overexpressing cells. Biofilm formation (a,d) and swimming (b,e) and swarming motility (c,f).
Discussion
In the current study, a collection of plasmids overexpressing 99 experimentally validated E. coli sRNAs was constructed and used to examine the functions of individual sRNAs in biofilm formation and associated phenotypes. Thirty-three of the sRNAs affected biofilm formation, swimming or swarming motility and formation of type I and curli fimbria by >1.5-fold (Table 1 and Fig. 11). However, it should be noted that the observed phenotypes would be the cumulative results of direct and/or indirect effects caused by long-term induction of sRNAs.
Venn diagram of sRNAs differentially affecting biofilm formation and related phenotypes.
sRNAs that increase and decrease biofilm formation >1.5-fold are shown in boxes and ellipses, respectively. All sRNAs except for MicA and McaS in the Venn diagram inhibit one or more biofilm-related phenotypes. MicA that increases swimming motility >1.5-fold is marked ‘*’, McaS that increases swarming motility >1.5-fold ‘**’ and CsrB and CsrC that generate more reddish color on Congo red plates ‘†’. FnrS and SroC shown outside the Venn diagram affected biofilm formation positively and negatively, respectively, without affecting the biofilm-related phenotypes.
Among the 18 sRNAs affecting biofilm formation, 12 caused a decrease while 6 induced an increase. Notably, swarming was decreased by 25 sRNAs but increased by McaS only, while swimming was suppressed by 9 sRNAs and increased by MicA only. Curli formation was suppressed by 14 sRNAs but activated by CsrB and CsrC. Interestingly, CsrB and CsrC promoted both biofilm and curli formation. Conversely, however, RseX and SgrS, other sRNAs that enhanced biofilm formation, repressed curli formation. The remaining biofilm-promoting sRNAs, Och5 and GcvB, suppressed swimming and swarming, respectively. MicA, which induced an increase in swimming, suppressed biofilm formation only slightly, but both swarming motility and type I fimbriae formation to a significant extent. McaS, which caused an increase in swarming, severely inhibited both biofilm and curli fimbriae formation. Type I fimbriae formation was suppressed by 5 sRNAs, all of which also inhibited biofilm formation, suggesting that these processes are closely related and that cell attachment plays an important role in the development of biofilm. While the involvement of MicA and RybB in type I fimbriae formation has been previously documented, DsrA, IS118 and MicM sRNAs were identified for the first time in this study. Except for type I fimbriae formation, biofilm development was not related to repression of any of the four phenotypes. The majority of sRNAs suppressed swarming motility and curli fimbriae. Interestingly, IS118, which is yet to be characterized, suppressed all phenotypes, including biofilm formation. FnrS and SroC affected only biofilm formation positively and negatively, respectively. CyaR and OmrB specifically suppressed curli fimbriae formation, RybB type I fimbriae formation and GlmY swimming. Several sRNAs (RyfD, RdlC, MicC, GadY, SdsR, RyeF and GcvB) repressed swarming only. While most sRNAs effective in biofilm formation, motility, and/or fimbriae formation have been identified as Hfq-dependent, some Hfq-independent sRNAs, such as CsrB, CsrC, RdlB, RdlC, RyfA, RyfB, RyfD and Och5, are also involved in these processes.
Involvement of sRNAs in motility and biofilm formation has been documented recently. Limited sRNAs are reported to directly affect biofilm formation and motility. ArcZ sRNA is a major regulator of rdar (red, dry and rough) biofilm development in Salmonella60. Our experiments showed that overexpression of ArcZ in E. coli leads to suppression of swimming and swarming motility as well as biofilm formation. McaS acts as a positive regulator of biofilm formation by activating pgaABCD operon54, the cell-bound exopolysaccharide adhesin. In our study, McaS increased swarming motility, but repressed biofilm and curli fimbriae formation. The reasons underlying this discrepancy with regard to effects on biofilm formation remain to be established. Besides previously known McaS, CsrB and CsrC57,58,59, we identified three more sRNAs, DicF, GadY and SdsR, as positive regulators of pgaA. Since CsrB and CsrC enhanced biofilm formation and much highly activated pgaA expression compared to the other sRNAs, pgaA expression more than threshold levels seems to be required for induction of biofilm formation. Previously, De Lay and Gottesman used a collection of plasmids overexpressing 26 Hfq-dependent sRNAs to perform phenotypic screening of swimming motility31. The group found that ArcZ, OmrA, OmrB and OxyS repress swimming motility, while McaS increases swimming motility. Moreover, this regulation occurs through flhDC. Their experiments additionally showed that MicA increases swimming motility in a manner not associated with flhDC. In our study, ArcZ, OmrA, OxyS and DicF suppressed swimming motility with down-regulation of flhD, while OmrB and McaS, which showed null and positive effects on flhD expression, respectively, had no significant effects on swimming motility. SdsR that moderately down-regulated flhD expression displayed little change in swimming motility. This discrepancy may be attributed to differences in the genetic backgrounds of strains used by the two groups. Since some stocks of strain MG1655 are reported to have the IS element inserted upstream of the flhDC operon61, which could activate the flhDC promoter and increase motility, we checked our laboratory stock of this strain. The results showed that the IS1 element was transposed in the flhDC promoter region (Supplementary Fig. 4). However, the reason for significant enhancement of swarming motility by McaS sRNA remains to be determined.
The impact of some sRNAs on biofilm formation can be explained in terms of their known functions. CsrB and CsrC are antagonists of CsrA protein and E. coli cells lacking CsrA are reported to increase biofilm formation and activate biofilm disposal62. We found that overexpression of CsrB and CsrC led to increased biofilm and curli formation, but inhibited swarming motility. Since inhibition of swarming motility is not related to biofilm formation (Fig. 8), CsrA may be involved in linking the pathways of biofilm formation and curli synthesis.
Appropriate levels of RpoS are important for normal biofilm development. RpoS is differentially expressed during biofilm development63 and its absence or elevated levels leads to inhibition of biofilm formation64,65. Among three rpoS-activating sRNAs, ArcZ and DsrA severely inhibited biofilm formation, while repression by RprA was mild. Previously, we showed that overexpression of the three rpoS-activating sRNAs induces comparable levels of rpoS translation66. Therefore, the amount of RpoS is not critical, but other effects of the inducing signals appear important. In addition, the three rpoS-activating sRNAs differentially affected the four biofilm-related phenotypes. Specifically, ArcZ and DsrA repressed swimming and swarming motilities, DsrA additionally inhibited type I fimbriae formation and RprA suppressed swarming motility and curli fimbriae formation.
Jorgensen et al.67 reported that McaS, RprA and GcvB inhibit csgD translation through direct base-pairing. OmrA and OmrB have also been shown to repress csgD translation33. Although CsgD is a curli biosynthesis regulator, the effects of these sRNAs on curli formation were different. McaS, RprA, OmrA and OmrB inhibited curli formation, but not GcvB. Furthermore, CsrB, DicF, IS118, Och5 and SgrS we identified as additional repressors of csgD also showed different phenotypes of curli formation. The finding that suppression of csgD expression is not sufficient to inhibit curli formation suggests the presence of another regulatory step.
We have shown that except for the few sRNAs the sRNA gene knock-out had little effects on biofilm formation or related phenotypes. Deletion of only dsrA, gcvB, or arcZ showed opposite phenotypes to those upon overexpression of the corresponding sRNAs. We reason that some sRNAs may not be expressed enough to affect the processes in our experimental conditions or there might be redundancy of sRNAs acting on the processes. Nevertheless, we found additional effects of sRNA gene knock-out, such as a slight reduction of biofilm formation by micC knock-out and a slight reduction of swarming by rseX knock-out, which could not be expected from the phenotypes upon overexpression.
Biofilm development should be regulated precisely and dynamically according to time- or environment-specific requirements. sRNAs appear to regulate biofilm formation in distinct ways that are not fully co-related to motility and type I or curli fimbriae phenotypes, reflecting the complexity of the regulatory pathways involved in development of biofilm. It is possible that these sRNAs act via different mechanisms to link various environmental signals and the decision process for biofilm formation. Further detailed analyses are warranted to elucidate the roles of individual sRNAs in biofilm development.
Materials and Methods
Bacterial strains, plasmids and oligonucleotides
E. coli K-12 MG1655 strain was used for phenotypic analyses. For construction and propagation of plasmids, the E. coli strain, DH5α, was used. The hfq mutant strain was obtained from E. coli Keio strain collection68. E. coli strains GSO559, GSO563 and GSO567 carried csgD-, flhD- and pgaA-lacZ translational fusions, respectively54. For IPTG-inducible stable overexpression of each sRNA, the RNA expression vectors, pHM-tac69, pHMB1 and pHMB2, were employed. The pHMB1 plasmid was constructed by adding the modified rnpB terminator sequence70 to the region downstream of the HindIII cloning site of pHM-tac66. Plasmid pHMB2 was constructed by replacing the EcoRI cloning site of pHMB1 with SmaI for blunt-end ligation. The oligonucleotide sequences used for plasmid construction are listed in Supplementary Table 3. Plasmids pKD13 and pKD46 were used for λ Red-mediated recombination to generate sRNA knock-out strains71.
Construction of the sRNA expression library
To generate a collection of sRNA-expressing plasmids, each sRNA coding region was amplified from MG1655 genomic DNA via PCR with the primers described in Supplementary Table 3. sRNA genes were amplified so that they could be transcribed from their natural transcription +1 site and terminated either at their own transcriptional termination site or the modified rnpB terminator encoded within the vector sequence. In cases where transcription units were not fully known, 20 nt upstream chromosomal sequences were added to the predicted 5′ ends. To ensure termination of transcription, >25 nt downstream chromosomal sequences were added to the predicted 3′ ends or the identified ρ-independent terminators. For more efficient transcriptional initiation, an additional adenine nucleotide was incorporated, if necessary, to ensure that the start site for sRNAs was adenine. PCR products were digested with EcoRI/XbaI, SmaI/XbaI or EcoRI/HindIII, followed by ligation into pHM-tac, pHMB1, or pHMB2 plasmids. Ligation products were transformed into strain DH5α and selected on ampicillin-containing LB plates for propagation. For sRNAs with highly homologous sequences or less than 150 nt in length, coding DNAs were obtained from a direct gene synthesis service (Bioneer).
Construction of sRNA knock-out strains
sRNA knock-out strains were constructed in strain MG1655 using λ Red-mediated recombination with PCR fragments containing both the upstream 55 bp and the downstream 55 bp region of each sRNA gene, as previously described71. The kanamycin resistance cassette was inserted in the opposite direction of sRNA expression. To avoid disruption of the surrounding genes, the overlapping or nearby gene sequences were kept unchanged. In case of SgrS and SdsR, the entire sRNA sequences were deleted although their genes are overlapped with sgrT and ryeA, respectively. The replacement of each sRNA gene with the kanamycin resistance cassette was confirmed by PCR and sequencing analysis. Oligonucleotides used to generate sRNA knock-out strains are listed in in Supplementary Table S3.
RNA extraction and northern blot analysis
Cells were grown overnight in LB broth with 100 μg/mL ampicillin, where necessary. Overnight cultures were diluted 1:100 in fresh medium and growth continued to the exponential phase (OD600 ≈ 0.6). IPTG (1 mM) was added to cultures for sRNA overexpression. After 20 min, cultures were directly extracted using the acidic hot phenol method, as described previously70.
Northern blot analysis was performed as follows: 10 μg total RNAs were fractionated on a 5% polyacrylamide gel containing 7 M urea and electrotransferred onto a HybondTM-XL membrane (Amersham Biosciences) via TE70 ECL Semi-dry transfer unit (Amersham Biosciences) at 185 mA for 1 h. Membranes were hybridized with 5′-32P labeled oligonucleotide probes in Rapid-Hyb buffer (Amersham Biosciences) at 42 °C, according to the manufacturer’s instructions. In most cases, the probe rnpBXb1 was used for detection of overexpressed sRNA from library plasmids. In cases where sRNA was not detected with rnpBXb1, specific oligonucleotide probes were used (listed in Supplementary Table 3). Hybridization signals were assessed using Image Analyzer FLA7000 (Fuji).
Electrophoretic mobility shift assay
EMSA experiments were performed as previously described72. 5′-UTR regions of csgD and flhD and coding regions of sRNAs were amplified using PCR with primers containing the T7 promoter sequence. Oligonucleotides used for PCR amplification are listed in in Supplementary Table S3. RNAs were prepared by in vitro transcription using T7 RNA polymerase (Promega), with the PCR fragments as templates. 5′ end-labeled the csgD or flhD UTR (5 nM) was incubated with unlabeled sRNAs (0.5 or 2.5 μM) in 10 μl TMN buffer [100 mM Tris-acetate, pH 7.6, 500 mM NaOAc, 25 mM Mg(OAc)2] at 25 °C for 20 min. The reactions were then analyzed on a 5% (v/v) non-denaturing polyacrylamide gel at 4 °C.
Assay for biofilm formation
Overnight cultures of MG1655 cells containing individual sRNA overexpression plasmids were diluted 100-fold into 100 μL of fresh LB medium in 96-well microtiter plates (polystyrene; SPL Lifesciences Cat. 34296) containing 1 mM IPTG and 100 μg/mL ampicillin and cultured without shaking for 12 h at 30 °C. The amount of biofilm attached to the microtiter plate was measured via crystal violet staining. Specifically, after discarding cell cultures, plates were washed twice by submerging in distilled water and shaking out, followed by the addition of 125 μL 0.1% (w/v) crystal violet water solution to each well. After 10 min incubation for staining, plates were washed four times with distilled water. Next, 30% (v/v) acetic acid solution was added to solubilize stained crystal violet and OD550 estimated with the Emax microplate reader (Molecular Devices). OD550 values were divided by OD595 values of cell density to normalize all values per OD595 unit and termed ‘biofilm index’.
Assay for swimming/swarming motility
Swimming and swarming motilities were investigated on soft agar plates. A 1 μL aliquot of each overnight culture was inoculated using a pipette tip onto swim agar (0.3% Bacto Agar, 1% tryptone, 0.5% NaCl) or swarm agar (0.6% Eiken Agar, 0.5% glucose, 1% tryptone, 0.5% yeast extract, 0.5% NaCl) containing 1 mM IPTG and 100 μg/mL ampicillin. Agar plates were sealed with Saran Wrap to prevent dehydration. The swimming assay was performed at 30 °C for 12 h and swarming assay at 37 °C for 16 h. The diameter of the swimming circle or distance of swarming branch was measured and normalized against that of a control strain.
Assay for type I fimbriae expression
Mannose-specific type I fimbriae expression was monitored using the yeast agglutination assay. Stagnant overnight cultures of each strain and the same volume of 0.5% (w/v) yeast (Sigma, YSC2) suspension in PBS were mixed and aggregation estimated after 20 min incubation at room temperature by visual inspection. A 100th volume of 0.1% crystal violet solution was also added for enhanced observation.
Assay for curli expression
Production of curli fimbriae was determined based on uptake of red color on Congo red plates (LB agar without NaCl containing 1 mM IPTG, 100 μg/mL ampicillin, 40 μg/mL Congo red and 20 μg/mL Coomassie Blue). MG1655 cells harboring each sRNA overexpression plasmid were streaked onto Congo red plates and incubated for 48 h at 28 °C. Colonies displaying pink-white color were considered curli fimbriae-deficient.
β-galactosidase assay
Overnight cultures grown in LB were diluted 100-fold into fresh LB containing ampicillin (100 μg/mL) and grown at 37 °C for 1.5 h. The lacZ fused target gene was induced by adding 0.2% arabinose and sRNA expression was simultaneously induced by 1 mM IPTG. After 1.5-h induction, β-galactosidase activities were determined, as described previously73.
Additional Information
How to cite this article: Bak, G. et al. Identification of novel sRNAs involved in biofilm formation, motility and fimbriae formation in Escherichia coli. Sci. Rep. 5, 15287; doi: 10.1038/srep15287 (2015).
References
Rivas, E., Klein, R. J., Jones, T. A. & Eddy, S. R. Computational identification of noncoding RNAs in E. coli by comparative genomics. Curr Biol. 11, 1369–1373 (2001).
Argaman, L. et al. Novel small RNA-encoding genes in the intergenic regions of Escherichia coli. Curr Biol. 11, 941–950 (2001).
Chen, S. et al. A bioinformatics based approach to discover small RNA genes in the Escherichia coli genome. Biosystems. 65, 157–177 (2002).
Vogel, J. et al. RNomics in Escherichia coli detects new sRNA species and indicates parallel transcriptional output in bacteria. Nucleic Acids Res. 31, 6435–6443 (2003).
Zhang, A. et al. Global analysis of small RNA and mRNA targets of Hfq. Mol Microbiol. 50, 1111–1124 (2003).
Wassarman, K. M., Repoila, F., Rosenow, C., Storz, G. & Gottesman, S. Identification of novel small RNAs using comparative genomics and microarrays. Genes Dev. 15, 1637–1651 (2001).
Raghavan, R., Groisman, E. A. & Ochman, H. Genome-wide detection of novel regulatory RNAs in E. coli. Genome Res. 21, 1487–1497 (2011).
Tjaden, B. et al. Transcriptome analysis of Escherichia coli using high-density oligonucleotide probe arrays. Nucleic Acids Res. 30, 3732–3738 (2002).
Waters, L. S. & Storz, G. Regulatory RNAs in bacteria. Cell. 136, 615–628 (2009).
Gottesman, S. & Storz, G. Bacterial Small RNA Regulators: Versatile Roles and Rapidly Evolving Variations. Cold Spring Harb Perspect Biol. 3, a003987 (2010).
Storz, G., Vogel, J. & Wassarman, K. M. Regulation by small RNAs in bacteria: expanding frontiers. Mol Cell. 43, 880–91 (2011).
Sharma, C. & Heidrich, N. Small RNAs and virulence in bacterial pathogens. RNA Biol. 9, 361–363 (2012).
Toledo-Arana, A., Repoila, F. & Cossart, P. Small noncoding RNAs controlling pathogenesis. Curr Opin Microbiol. 10, 182–188 (2007).
Papenfort, K. & Vogel, J. Regulatory RNA in bacterial pathogens. Cell Host Microbe. 8, 116–127 (2010).
Hoe, C.-H., Raabe, C. a, Rozhdestvensky, T. S. & Tang, T.-H. Bacterial sRNAs: regulation in stress. Int J Med Microbiol. 303, 217–29 (2013).
Vogel, J. & Luisi, B. F. Hfq and its constellation of RNA. Nat Rev Microbiol. 9, 578–89 (2011).
De Lay, N., Schu, D. J. & Gottesman, S. Bacterial small RNA-based negative regulation: Hfq and its accomplices. J Biol Chem. 288, 7996–8003 (2013).
Sobrero, P. & Valverde, C. The bacterial protein Hfq: much more than a mere RNA-binding factor. Crit Rev Microbiol. 38, 276–99 (2012).
Hall-Stoodley, L., Costerton, J. W. & Stoodley, P. Bacterial biofilms: from the natural environment to infectious diseases. Nat Rev Microbiol. 2, 95–108 (2004).
Karatan, E. & Watnick, P. Signals, regulatory networks and materials that build and break bacterial biofilms. Microbiol Mol Biol Rev. 73, 310–47 (2009).
Lenz, A. P., Williamson, K. S., Pitts, B., Stewart, P. S. & Franklin, M. J. Localized gene expression in Pseudomonas aeruginosa biofilms. Appl Environ Microbiol. 74, 4463–71 (2008).
Beloin, C. et al. Global impact of mature biofilm lifestyle on Escherichia coli K-12 gene expression. Mol Microbiol. 51, 659–674 (2004).
Ren, D., Bedzyk, L. A., Thomas, S. M., Ye, R. W. & Wood, T. K. Gene expression in Escherichia coli biofilms. Appl Microbiol Biotechnol. 64, 515–524 (2004).
Schembri, M. A., Kjaergaard, K. & Klemm, P. Global gene expression in Escherichia coli biofilms. Mol Microbiol. 48, 253–267 (2003).
Niba, E. T., Naka, Y., Nagase, M., Mori, H. & Kitakawa, M. A genome-wide approach to identify the genes involved in biofilm formation in E. coli. DNA Res. 14, 237–246 (2007).
Van Houdt, R. & Michiels, C. W. Role of bacterial cell surface structures in Escherichia coli biofilm formation. Res Microbiol. 156, 626–633 (2005).
Michaux, C., Verneuil, N., Hartke, A. & Giard, J.-C. Physiological roles of small RNA molecules. Microbiology. 160, 1007–19 (2014).
Guillier, M., Gottesman, S. & Storz, G. Modulating the outer membrane with small RNAs. Genes Dev. 20, 2338–2348 (2006).
Papenfort, K. & Vogel, J. Multiple target regulation by small noncoding RNAs rewires gene expression at the post-transcriptional level. Res Microbiol. 160, 278–287 (2009).
Mandin, P. & Gottesman, S. Integrating anaerobic/aerobic sensing and the general stress response through the ArcZ small RNA. EMBO J. 29, 3094–3107 (2010).
De Lay, N. & Gottesman, S. A complex network of small non-coding RNAs regulate motility in Escherichia coli. Mol Microbiol. 86, 524–538 (2012).
Mika, F. & Hengge, R. Small Regulatory RNAs in the Control of Motility and Biofilm Formation in E. coli and Salmonella. Int J Mol Sci. 14, 4560–79 (2013).
Holmqvist, E. et al. Two antisense RNAs target the transcriptional regulator CsgD to inhibit curli synthesis. EMBO J. 29, 1840–1850 (2010).
Urban, J. H. & Vogel, J. Two seemingly homologous noncoding RNAs act hierarchically to activate glmS mRNA translation. PLoS Biol. 6, e64 (2008).
Lease, R. A. & Belfort, M. Riboregulation by DsrA RNA: trans-actions for global economy. Mol Microbiol. 38, 667–672 (2000).
Frohlich, K. S., Papenfort, K., Berger, A. A. & Vogel, J. A conserved RpoS-dependent small RNA controls the synthesis of major porin OmpD. Nucleic Acids Res. 40, 3623–3640 (2012).
Park, H., Bak, G., Kim, S. C. & Lee, Y. Exploring sRNA-mediated gene silencing mechanisms using artificial small RNAs derived from a natural RNA scaffold in Escherichia coli. Nucleic Acids Res. 41, 3787–3804 (2013).
Pratt, L. A. & Kolter, R. Genetic analysis of Escherichia coli biofilm formation: roles of flagella, motility, chemotaxis and type I pili. Mol Microbiol. 30, 285–293 (1998).
Verstraeten, N. et al. Living on a surface: swarming and biofilm formation. Trends Microbiol. 16, 496–506 (2008).
Harshey, R. M. Bacterial motility on a surface: many ways to a common goal. Annu Rev Microbiol. 57, 249–273 (2003).
Vanderpool, C. K. & Gottesman, S. Involvement of a novel transcriptional activator and small RNA in post-transcriptional regulation of the glucose phosphoenolpyruvate phosphotransferase system. Mol Microbiol. 54, 1076–1089 (2004).
Udekwu, K. I. et al. Hfq-dependent regulation of OmpA synthesis is mediated by an antisense RNA. Genes Dev. 19, 2355–2366 (2005).
Rasmussen, A. A. et al. Regulation of ompA mRNA stability: the role of a small regulatory RNA in growth phase-dependent control. Mol Microbiol. 58, 1421–1429 (2005).
Romling, U. Characterization of the rdar morphotype, a multicellular behaviour in Enterobacteriaceae. Cell Mol Life Sci. 62, 1234–1246 (2005).
Prigent-Combaret, C. et al. Developmental pathway for biofilm formation in curli-producing Escherichia coli strains: role of flagella, curli and colanic acid. Environ Microbiol. 2, 450–64 (2000).
Schilling, J. D., Mulvey, M. A. & Hultgren, S. J. Structure and Function of Escherichia coli Type 1 Pili: New Insight into the Pathogenesis of Urinary Tract Infections. J Infect Dis. 183, S36–S40 (2001).
Hasman, H., Schembri, M. a. & Klemm, P. Antigen 43 and Type 1 Fimbriae Determine Colony Morphology of Escherichia coli K-12. J Bacteriol. 182, 1089–1095 (2000).
Johansen, J., Rasmussen, A. A., Overgaard, M. & Valentin-Hansen, P. Conserved small non-coding RNAs that belong to the sigmaE regulon: role in down-regulation of outer membrane proteins. J Mol Biol. 364, 1–8 (2006).
Gogol, E. B., Rhodius, V. a, Papenfort, K., Vogel, J. & Gross, C. a. Small RNAs endow a transcriptional activator with essential repressor functions for single-tier control of a global stress regulon. Proc Natl Acad Sci USA 108, 12875–80 (2011).
Jørgensen, M. G. et al. Small regulatory RNAs control the multi-cellular adhesive lifestyle of Escherichia coli. Mol Microbiol. 84, 36–50 (2012).
Bordeau, V. & Felden, B. Curli synthesis and biofilm formation in enteric bacteria are controlled by a dynamic small RNA module made up of a pseudoknot assisted by an RNA chaperone. Nucleic Acids Res. 42, 4682–4696 (2014).
Ogasawara, H., Yamamoto, K. & Ishihama, A. Role of the biofilm master regulator CsgD in cross-regulation between biofilm formation and flagellar synthesis. J Bacteriol. 193, 2587–2597 (2011).
Mika, F. et al. Targeting of csgD by the small regulatory RNA RprA links stationary phase, biofilm formation and cell envelope stress in Escherichia coli. Mol Microbiol. 84, 51–65 (2012).
Thomason, M. K., Fontaine, F., De Lay, N. & Storz, G. A small RNA that regulates motility and biofilm formation in response to changes in nutrient availability in Escherichia coli. Mol Microbiol. 84, 17–35 (2012).
Chevance, F. F. V. & Hughes, K. T. Coordinating assembly of a bacterial macromolecular machine. Nat Rev Microbiol. 6, 455–465 (2008).
Itoh, Y. et al. Roles of pgaABCD genes in synthesis, modification and export of the Escherichia coli biofilm adhesin poly-beta-1,6-N-acetyl-D-glucosamine. J Bacteriol. 190, 3670–3680 (2008).
Liu, M. Y. et al. The RNA molecule CsrB binds to the global regulatory protein CsrA and antagonizes its activity in Escherichia coli. J Biol Chem. 272, 17502–17510 (1997).
Wang, X. et al. CsrA post-transcriptionally represses pgaABCD, responsible for synthesis of a biofilm polysaccharide adhesin of Escherichia coli. Mol Microbiol. 56, 1648–1663 (2005).
Weilbacher, T. et al. A novel sRNA component of the carbon storage regulatory system of Escherichia coli. Mol Microbiol. 48, 657–670 (2003).
Claudia, M. et al. Hfq and Hfq-dependent small RNAs are major contributors to multicellular development in Salmonella enterica serovar typhimurium. RNA Biol. 9, 489–502 (2012).
Barker, C. S., Pru, B. M. & Matsumura, P. Increased Motility of Escherichia coli by Insertion Sequence Element Integration into the Regulatory Region of the flhD Operon. J Bacteriol. 186, 7529–7537 (2004).
Jackson, D. W. et al. Biofilm formation and dispersal under the influence of the global regulator CsrA of Escherichia coli. J Bacteriol. 184, 290–301 (2002).
Ito, A., May, T., Taniuchi, A., Kawata, K. & Okabe, S. Localized expression profiles of rpoS in Escherichia coli biofilms. Biotechnol Bioeng. 103, 975–983 (2009).
Ferrieres, L., Thompson, A. & Clarke, D. J. Elevated levels of sigma S inhibit biofilm formation in Escherichia coli: a role for the Rcs phosphorelay. Microbiology. 155, 3544–3553 (2009).
Adams, J. L. & McLean, R. J. Impact of rpoS deletion on Escherichia coli biofilms. Appl Env Microbiol . 65, 4285–4287 (1999).
Bak, G., Han, K., Kim, D. & Lee, Y. Roles of rpoS-activating small RNAs in pathways leading to acid resistance of Escherichia coli. Microbiologyopen . 3, 15–28 (2014).
Jorgensen, M. G. et al. Small regulatory RNAs control the multi-cellular adhesive lifestyle of Escherichia coli. Mol Microbiol. 84, 36–50 (2012).
Baba, T. et al. Construction of Escherichia coli K-12 in-frame, single-gene knockout mutants: the Keio collection. Mol Syst Biol 2, 2006 0008 (2006).
Han, K., Kim, K. S., Bak, G., Park, H. & Lee, Y. Recognition and discrimination of target mRNAs by Sib RNAs, a cis-encoded sRNA family. Nucleic Acids Res. 38, 5851–5866 (2010).
Kim, S., Kim, H., Park, I. & Lee, Y. Mutational analysis of RNA structures and sequences postulated to affect 3′ processing of M1 RNA, the RNA component of Escherichia coli RNase P. J Biol Chem. 271, 19330–19337 (1996).
Datsenko, K. A. & Wanner, B. L. One-step inactivation of chromosomal genes in Escherichia coli K-12 using PCR products. Proc Natl Acad Sci USA 97, 6640–6645 (2000).
Bak, G., Han, K., Kim, K. & Lee, Y. Electrophoretic mobility shift assay of RNA-RNA complexes. Methods Mol Biol. 1240, 153–163 (2015).
Zhang, X. & Bremer, H. Control of the Escherichia coli rrnB P1 promoter strength by ppGpp. J Biol Chem. 270, 11181–11189 (1995).
Acknowledgements
This study was supported by the National Research Foundation of Korea (NRF) Grant by the Korea government (MSIP) (2010-0029167; 2011-0020322) and the Intelligent Synthetic Biology Center of Global Frontier Project funded by MSIP (2012M3A6A8055678). The authors would like to thank Drs. S. Gottesman and N. Majdalani for providing pBRplac-based sRNA library strains, Dr. G. Storz for providing strains PM1205, MG1655, GSO559, GSO563 and GSO567 and NBRP-E.coli at NIG for providing E. coli strains of the Keio collection.
Author information
Authors and Affiliations
Contributions
All authors designed the research. G.B. and J.L. performed the experiments, analyzed the data and contributed equally to the study. D.K., S.S., K.-S.K., J.Y.L. and B.-S.C. carried out special experimental work and analyzed the data. G.B., J.L. and Y.L. co-wrote the manuscript. All authors contributed to editing the manuscript.
Ethics declarations
Competing interests
The authors declare no competing financial interests.
Electronic supplementary material
Rights and permissions
This work is licensed under a Creative Commons Attribution 4.0 International License. The images or other third party material in this article are included in the article’s Creative Commons license, unless indicated otherwise in the credit line; if the material is not included under the Creative Commons license, users will need to obtain permission from the license holder to reproduce the material. To view a copy of this license, visit http://creativecommons.org/licenses/by/4.0/
About this article
Cite this article
Bak, G., Lee, J., Suk, S. et al. Identification of novel sRNAs involved in biofilm formation, motility and fimbriae formation in Escherichia coli. Sci Rep 5, 15287 (2015). https://doi.org/10.1038/srep15287
Received:
Accepted:
Published:
DOI: https://doi.org/10.1038/srep15287
This article is cited by
-
ProQ binding to small RNA RyfA promotes virulence and biofilm formation in avian pathogenic Escherichia coli
Veterinary Research (2023)
-
Genome-wide identification of Kanamycin B binding RNA in Escherichia coli
BMC Genomics (2023)
-
The two sRNAs OmrA and OmrB indirectly repress transcription from the LEE1 promoter of enteropathogenic Escherichia coli
Folia Microbiologica (2023)
-
RNA landscape of the emerging cancer-associated microbe Fusobacterium nucleatum
Nature Microbiology (2021)
-
Exploring the antibacterial potential and unraveling the mechanism of action of non-doped and heteroatom-doped carbon nanodots
Journal of Nanoparticle Research (2020)